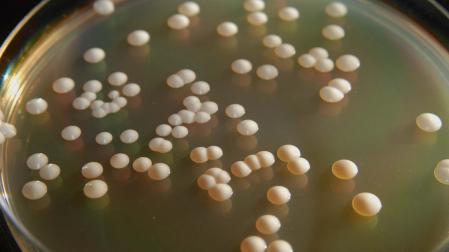
La levadura ‘Saccharomyces cerevisiae’ puede utilizar diferentes fuentes de carbono para producir bioetanol.
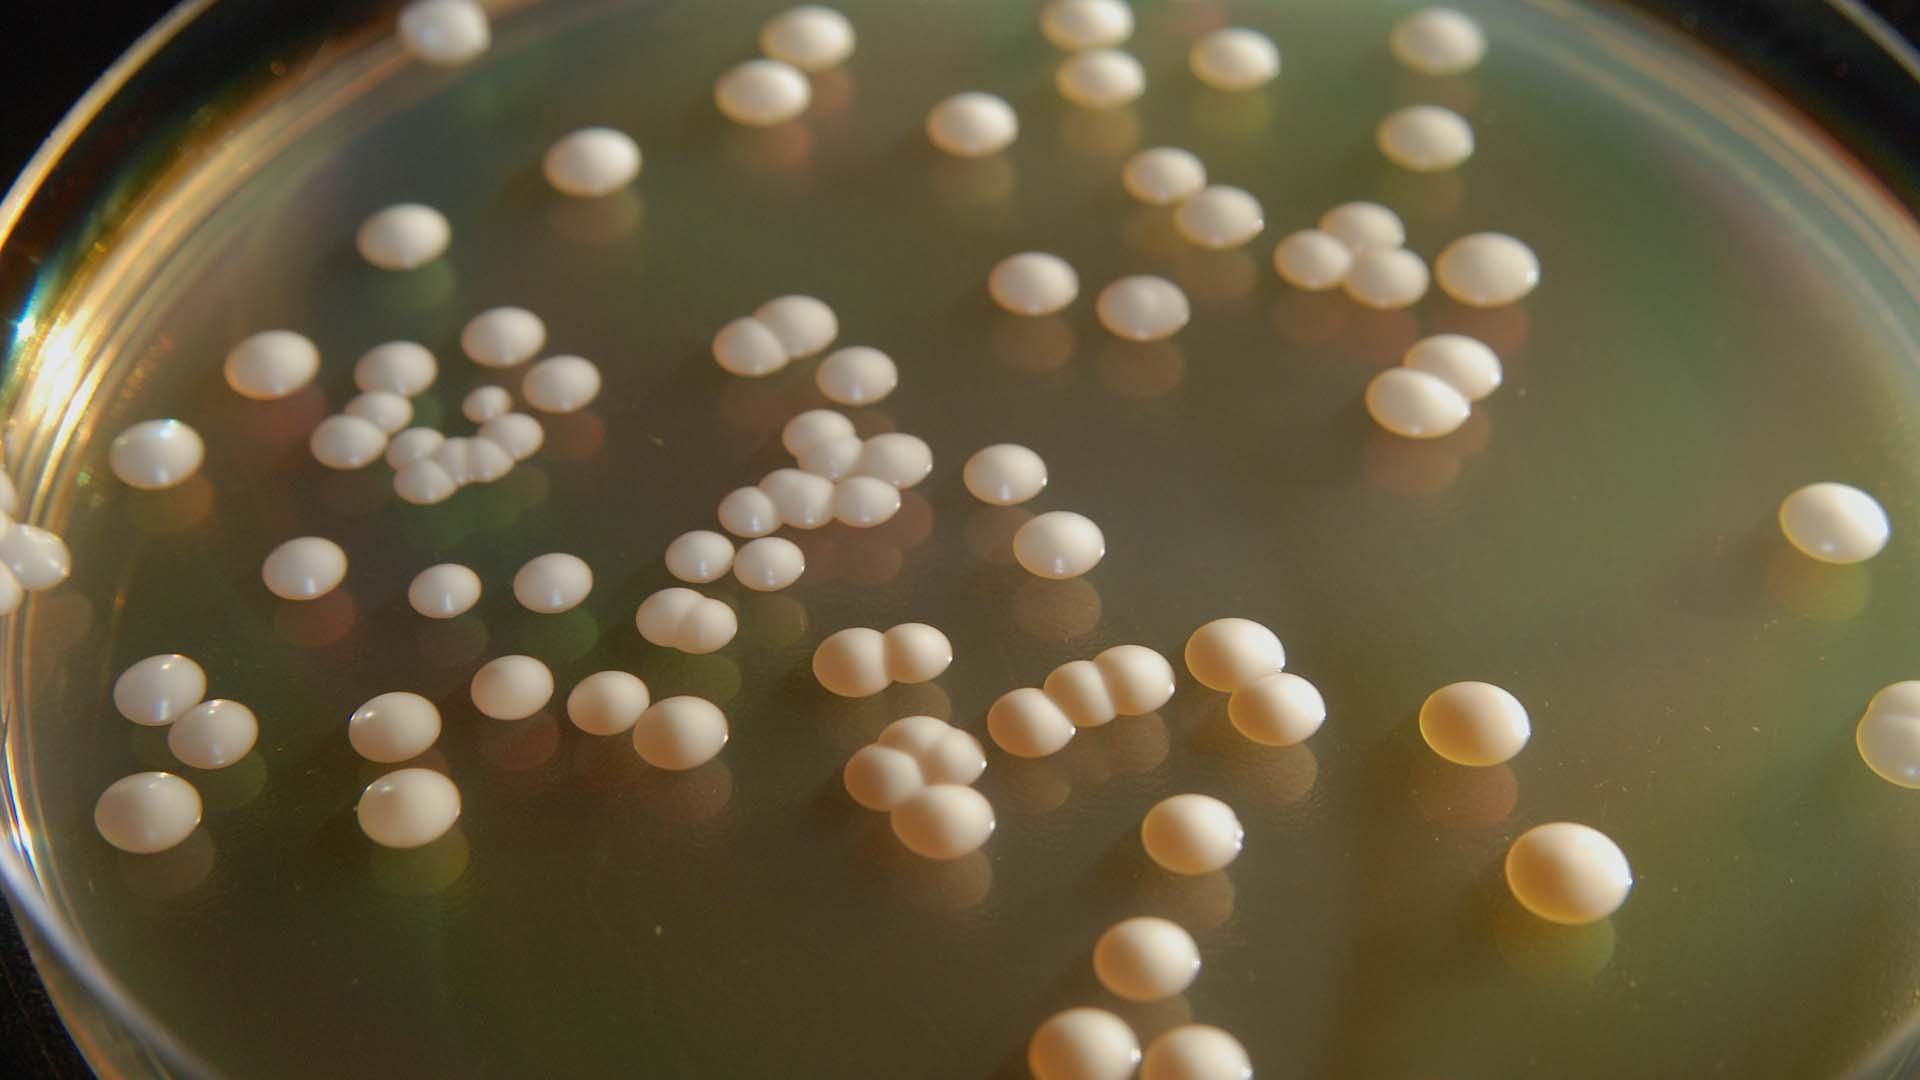
La levadura ‘Saccharomyces cerevisiae’ puede utilizar diferentes fuentes de carbono para producir bioetanol.

Sostenibilidad
Más allá de la cerveza y el pan: cómo las levaduras pueden ayudarnos a combatir el cambio climático

Publicado el 10/01/2023 a las 07:44
La levadura Saccharomyces cerevisiae se lleva utilizando desde hace siglos para elaborar de bebidas fermentadas como la cerveza y el vino, así como para la producción de pan. Por eso se la conoce como “levadura de panadería”.
Pero este superhongo microscópico unicelular puede ayudarnos en muchas más tareas. Incluso, en la transición energética del transporte y en la implantación de una economía circular.


HACIA UNA ECONOMÍA MÁS SOSTENIBLE
En la situación actual de crisis energética en la que la preocupación por el cambio climático es global, implementar una bioeconomía sostenible es una prioridad. Para lograr este objetivo, es necesario obtener bioproductos renovables capaces de reemplazar compuestos derivados de residuos fósiles, que contribuyen al calentamiento global además de ser de limitada disponibilidad.
En ese contexto, la Comisión Europea ha adoptado un conjunto de propuestas para adaptar las políticas de la UE en materia de clima, energía, transporte y fiscalidad con el fin de reducir las emisiones netas de gases de efecto invernadero en al menos un 55 % de aquí a 2030.
Todas esas medidas se reflejan en el Pacto Verde Europeo que promueve, por ejemplo, transformar nuestra economía y nuestras sociedades haciendo que el transporte sea sostenible para todos.
Del mismo modo, las Naciones Unidas ha fijado 17 Objetivos de Desarrollo Sostenible entre los que se incluye aumentar la presencia de energías renovables y favorecer actividades industriales innovadoras como las del sector biotecnológico.
En este sentido, los procesos biotecnológicos basados en levaduras son una alternativa muy interesante para el establecimiento de una economía circular.
LEVADURAS PARA PRODUCIR BIOCOMBUSTIBLES
Las levaduras pueden generar compuestos industrialmente relevantes a partir de residuos orgánicos. Además, lo hacen de una manera rentable y respetuosa con el medio ambiente. Para ello, consumen las fuentes de carbono residuales (azúcares o ácidos grasos de cadena corta) que, una vez dentro de la célula, se transforman en el producto de interés gracias al metabolismo eficiente de las levaduras.
En las últimas décadas, S. cerevisiae se ha empleado como factoría celular para la producción de productos farmacéuticos, biocatalizadores industriales, aditivos alimentarios y biocombustibles renovables como el bioetanol.
El bioetanol se utiliza como sustitutivo de la gasolina en el transporte. Su uso en mezclas de gasolina está ampliamente distribuido y es incluso obligatorio en algunos países como España. Por ello, es el biocombustible con una tecnología de obtención más arraigada y con mayor producción mundial.
De hecho, en los últimos años se han instalado varias biorrefinerías de producción de bioetanol por toda Europa, como St1 Biofuels Oy (Finlandia), Borregaard Industries AB (Noruega), Procethol2G (Francia) y Perseo Biotechnology (España).
A pesar de ser una productora de bioetanol muy eficiente, S. cerevisiae no utiliza fácilmente todas las fuentes de carbono derivadas de los residuos lignocelulósicos y no tiene la capacidad natural de acumular una gran cantidad de lípidos en sus células. Esto la hace inviable para producir combustibles como biodiesel y otros compuestos oleoquímicos.
OTRAS ESPECIES INTERESANTES
Hasta la fecha, se han identificado y caracterizado más de 2 000 especies de otras levaduras conocidas como “no convencionales” que están ganando progresivamente mucha atención para ser empleadas en diferentes aplicaciones biotecnológicas.
Yarrowia lipolytica, Komagataella phaffii, Hansenula polymorpha, Kluyveromyces lactis, Kluyveromyces marxianus, Zygosaccharomyces bailii y Rhodosporidium toruloides se encuentran entre las más utilizados y mejor estudiadas. Muchas de estas especies pueden crecer y fermentar en amplias condiciones de proceso y pueden utilizar una amplia variedad de fuentes de carbono renovables.


Además, algunas levaduras oleaginosas como Rhodotorula glutinis y Lipomyces starkeyi puede acumular lípidos hasta un 60 %–70 % de su peso, lo que ofrece un gran potencial comercial para la producción de biocombustibles como el biodiesel y la generación de bioproductos lipídicos de alto valor como los carotenoides y los tensioactivos.
Debido a su amplia biodiversidad, todavía hay muchas aplicaciones basadas en levaduras que quedan sin explorar. Estas serán clave para avanzar hacia una bioeconomía circular centrada en la utilización y valorización de residuos orgánicos para la producción de biocombustibles y bioproductos.
Elia Tomás Pejó, Investigadora Titular en Biotecnología, IMDEA ENERGÍA
Este artículo fue publicado originalmente en The Conversation. Lea el original.